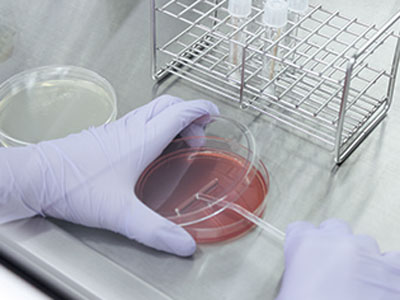

お悩み別ケア
2017.7.21
ニキビや揺らぎ肌に悩んでいる人必見!おすすめビタミン系or免疫アップ系コスメ
「菌ケア」最新情報2
「自分の菌を培養し、肌に戻す「美肌バンク」
自分の肌にある良い菌を培養し、肌に戻す新アプローチが実用化。1回で10億個の美肌菌を肌に塗布。臨床研究では、肌の水分量・油分が増加する結果が出ているそう。

培養した美肌菌を就寝前に1瓶、肌に塗布。問バイオジェノミクス ☎0957-54-3529
培養した美肌菌を就寝前に1瓶、肌に塗布。問バイオジェノミクス ☎0957-54-3529
『美的』7月号掲載
撮影/河野 望(静物)、高嶋佳代(取材) スタイリスト/山本揺奈 イラスト&モチーフ/藤原千晶 デザイン/GRACE.inc 構成/もりたじゅんこ
※価格表記に関して:2021年3月31日までの公開記事で特に表記がないものについては税抜き価格、2021年4月1日以降公開の記事は税込み価格です。



















